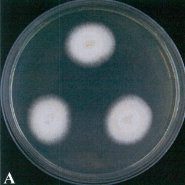
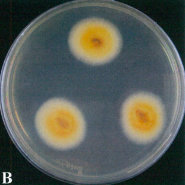
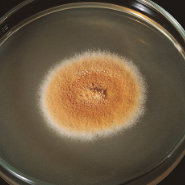

分子活性分析および高活性化研究、成分の分離分析(薄層クロマトグラフィー:TLC)、核磁気共鳴(NMR)、高速液体クロマトグラフィー(HPLC)、紫外分光器(UV)、液体クロマトグラフィー、ダイオードアレイ(DAD)、さらには質量分析(LC-ESI(+)-MS/MS)、極性の違いを利用して対象物を抽出・分離・精製し、純粋な化合物を獲得してきました。そして、この化合物を用いて分子構造解析を行い、データベースを構築し、確立しました。
*医薬品グレードのキノコは、実体と活性化合物の薬理学的分析、毒性学と動物モデルの検証分析、前臨床研究を行っています